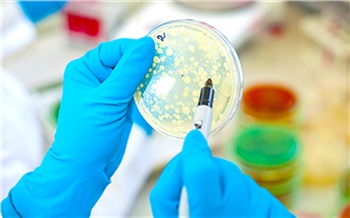
В сыре, котлетах и салате из Красноярского края специалисты нашли опасные бактерии

Эти темы обсуждались на координационном совещании по обеспечению правопорядка в регионе.
Опубликовано: 16:16, декабря 6, 2025 в: «Главные новости»; Сообщает источник: newslab.ru; Поделитесь новостью:





«Сбер» призвал россиян не общаться с телефонными мошенниками
В Сбербанке призвали граждан России быть бдительными и не разговаривать с телефонными мошенниками в праздничные дни. За последнюю неделю в стране про …

В Лондоне подожгли отель с нелегальными мигрантами
В Лондоне подожгли гостиницу Thistle City Barbican, где размещаются нелегальные мигранты, по следам инцидента задержан один человек. Об этом говоритс …

Патрушев призвал расширить транспортные возможности рек Красноярского края
Транспортные возможности рек Красноярского края, прежде всего Енисея, необходимо расширить для использования потенциала Трансарктического транспортно …

Губернатор наградил еще 37 выдающихся жителей Красноярского края
Михаил Котюков вручил государственные, ведомственные и региональные награды за высокие достижения 37 жителям Красноярского края. …

Губернатор вручил жителям Красноярского края государственные награды
Глава Красноярского края Михаил Котюков вручил 34 жителям региона краевые и государственные награды. …

Губернатор Красноярского края поздравил педагогов с профессиональным праздником
Губернатор Красноярского края Михаил Котюков посетил родную школу и поздравил педагогов с Днем учителя. …

Губернатор Красноярского края отправил подарки детям из Свердловска
В рамках всероссийской акции «Ёлка желаний» губернатор Красноярского края Михаил Котюков отправил подарки детям из Свердловска. …

Губернатор Красноярского края встретился с Генеральным секретарем АРАССВА
Губернатор Красноярского края Михаил Котюков провел встречу с Генеральным секретарем Ассоциации региональных администраций стран Северо-Восточной Ази …

Губернатор Красноярского края предупредил о второй волне урагана
Губернатор Красноярского края Михаил Котюков сообщил, что первая волна урагана, из-за которого десятки населенных пунктов остались без света, закончи …

Назван главный инструмент для борьбы с телефонными мошенниками
В условиях роста телефонного мошенничества и распространения дипфейков рекомендуется проявлять крайнюю степень недоверия к любым звонкам, связанным с …

54% южан в 2024 году столкнулись с телефонными мошенниками
По данным опроса* ВТБ, в 2024 году 54% россиян сталкивались с телефонным или интернет-мошенничеством и смогли противостоять злоумышленникам, сохранив …

Правительство России борется с телефонными и интернет-мошенниками
Правительство РФ разработало и вскоре начнет реализовывать масштабный план по борьбе с телефонным и интернет-мошенничеством. Премьер-министр Михаил М …

Губернатор Красноярского края вручил награды организаторам патриотических мероприятий
Губернатор Михаил Котюков вручил памятные медали, грамоты и благодарственные письма жителям Красноярья, которые в 2025 году стали организаторами меро …

«Спасибо, что вы рядом!»: губернатор Красноярского края поздравил женщин с 8 Марта
Накануне праздника Михаил Котюков вручил жительницам Красноярья, которые внесли значительный вклад в развитие региона, государственные и ведомственны …

В Совфеде заявили, что борьба с телефонными мошенниками будет бесконечной
Председатель комиссии Совета Федерации РФ по информационной политике Алексей Пушков заявил, что борьба с телефонными и интернет-мошенниками бесконечн …

Россия борется с телефонными мошенниками: новый законопроект о SIM-боксах
Министерство цифрового развития, ФСБ и МВД России ведут разработку проекта закона, который также направлен на борьбу с телефонными мошенниками. Речь …

Губернатор Красноярского края вручил почетные знаки в честь 90-летия региона
Губернатор Красноярского края Михаил Котюков вручил 86 жителям почетные знаки в честь 90-летия региона. …

Губернатор Красноярского края обсудил с главами территорий реализацию муниципальной реформы
Михаил Котюков провел рабочую встречу с главами территорий, посвященную реализации в регионе первого этапа реформы местного самоуправления. …

Губернатор Красноярского края передал начальнику ГУФСИН ключи от новых автомобилей
23 новых специализированных автомобиля получили подразделения уголовно-исполнительной системы Красноярского края от правительства региона. …

Губернатор Красноярского края стал лауреатом Высшей юридической премии «Фемида»
Губернатор Красноярского края Михаил Котюков получил награду Высшей юридической премии «Фемида» в номинации «Государственное управление». …

Губернатор Красноярского края сыграл в баскетбол с гостями Кубка Ивана Ярыгина
Губернатор Красноярского края Михаил Котюков и его первый заместитель Сергей Пономаренко провели с гостями Кубка Ивана Ярыгина товарищеский матч по б …

Борьба с телефонными мошенниками — советы, которые помогут при спам-атаках
Телефонные звонки, особенно от продавцов, часто приходят в неподходящее время. Вопрос, как справиться с этой проблемой, остается актуальным уже много …

Период охлаждения могут ввести в России для борьбы с телефонными мошенниками
Москва. Период охлаждения могут ввести в России для борьбы с телефонными мошенниками. Такое предложение внес президент России Владимир Путин во время …

Жителю Тверской области вернут деньги, похищенные телефонными мошенниками
Органами прокуратуры проведена проверка по обращению 71-летнего жителя Старицкого округа о возмещении ущерба, причиненного преступлением. Введенный в …

Губернатор Красноярского края пообещал принять кадровые решения по школам, где произошли нападения Губернатор Красноярского края Михаил Котюков пообещал до конца недели принять кадровые решения в отношении сотрудников учебных учреждений, где были з …

Губернатор Хабаровского края призвал к осторожности на железнодорожных переездах «Хочу напомнить всем о необходимости неукоснительно соблюдать правила пересечения железнодорожных переездов», – обратился Губернатор Хабаровского кра …

Путин поручил усилить меры по борьбе с украинскими мошенниками Перед ФСБ и МВД поставлена задача разработать дополнительные меры по блокировке телефонных вызовов, осуществляемых с территорий Украины и других недр …

Федерация бодибилдинга России планирует усилить борьбу с допингом Федерация бодибилдинга России (ФББР) намерена активизировать борьбу с допингом в своем виде спорта и рассчитывает на поддержку со стороны Российского …

Путин поручил усилить борьбу с иностранным влиянием на нацполитику Президент России Владимир Путин поручил правительству усилить меры по борьбе с негативным информационным влиянием из-за рубежа на межнациональные отн …

Санду: следует усилить борьбу с коррупцией перед парламентскими выборами Действующий президент Молдавии Майя Санду, лидирующая во втором туре выборов главы государства, планирует перед парламентскими выборами 2025 года акт …

Володин призвал не вводить бабушек в «блуд с мигрантами» Председатель Госдумы Вячеслав Володин призвал не вводить пожилых женщин в «блуд с мигрантами» через фиктивные браки. Ранее Володин рассказал о поправ …

Володин призвал не вводить "бабушек в блуд" с мигрантами Спикер Государственной Думы Вячеслав Володин призвал противодействовать вовлечению пенсионерок в незаконные схемы заключения фиктивных браков с мигра …

Зеленский призвал "большие страны" усилить ПВО Украины "Большие страны" должны помочь Украине усилить ее противовоздушную оборону. Об этом заявил украинский президент Владимир Зеленский в своем Telegram-к …

Гладков призвал усилить контроль за расходами на помощь жителям приграничья Губернатор Белгородской области Вячеслав Гладков на совещании в облправительстве призвал подчиненных и представителей правоохранительных органов усил …

Кравцов призвал регионы усилить контроль за безопасностью школьников в морозы Главы регионов и местные администрации обязаны усилить внимание к вопросам безопасности и охраны здоровья школьников в связи с установившимися сильны …

Глава Минобороны Великобритании призвал усилить военную помощь Киеву Министр обороны Великобритании Джон Хили на предстоящем заседании Контактной группы по обороне Украины (Ukraine Defense Contact Group — UDCG или форм …

Макрон призвал усилить давление на Россию и поддержал новые санкции Президент Франции Эммануэль Макрон заявил о необходимости усиления давления на Россию, обвинив Москву в нежелании содействовать завершению конфликта …

Министр обороны Бельгии Франкен призвал усилить армию и подготовиться к худшему Глава Министерства обороны Бельгии Тео Франкен сделал заявление о необходимости укрепления оборонного потенциала страны для подготовки к самым худшим …

Зеленский призвал ЕС снизить потолок цен на нефть и усилить санкции против России Владимир Зеленский предложил включить в 18-й пакет санкций ЕС ограничения против нефтяной торговли, банков, поставщиков военного оборудования и призв …

Губернатор Никитин: нужно усилить наказание за неуплату алиментов По словам главы Новгородской области, в стране остро стоит вопрос содержания детей и уклонения от него. Чаще всего ребёнком приходится заниматься мат …

Губернатор позвал орловцев на борьбу с провокациями В Орловской области запущен проект «АнтиФейк». max.ru/a_klychkov Так называется «полностью официальная площадка», где будут заниматься опровержением …

«Союзмультфильм» подал в суд на бизнесвумен из Красноярского края «Союзмультфильм» подал в суд на бизнесвумен из Красноярского края за игрушку с волком из мультипликационного фильма «Жил-был пёс». …

Подростки на минивэне попали в ДТП на юге Красноярского края В селе Селиваниха Минусинского округа Красноярского края утром 3 января произошло ДТП с участием двух подростков. …

На юге Красноярского края убили пожилых супругов Супружескую пару пенсионеров нашли убитыми в собственной квартире в Минусинске на юге Красноярского края. Возбуждено уголовное дело, сообщает ГСУ СК …

Паводок разрушил три моста Красноярского края Оперативные службы сообщают, что дожди размывают опору второго путепровода. Проливные дожди в Красноярском крае несут значительные разрушения, а люде …

Назначен председатель правительства Красноярского края Сегодня на сессии Законодательного Собрания Красноярского края депутаты единогласно утвердили Алексея Медведева на пост председателя правительства ре …

Ребенок погиб в пожаре на юге Красноярского края В Минусинске Красноярского края в результате пожара в частном одноэтажном брусовом жилом доме погиб 12-летний мальчик и пострадали двое взрослых. …

60 ветеранов СВО из Красноярского края станут управленцами В Красноярском крае подвели итоги отбора в краевую кадровую программу «Сибирский характер». …

Назначен новый глава ГАИ Красноярского края Начальником управления Госавтоинспекции ГУ МВД России по Красноярскому краю стал 52-летний полковник полиции Сергей Молявко. …

Путин наградил еще две многодетные пары из Красноярского края Президент России Владимир Путин подписал указ о награждении медалями ордена «Родительская слава» многодетных семей Олимовых из Красноярск …

Огонь уничтожил несколько магазинов на юге Красноярского края Пожар уничтожил сразу несколько магазинов в селе Каратузское Красноярского края. Пострадавших нет, сообщает пресс-служба регионального МЧС в понедель …

В Заксобрании Красноярского края прошла донорская акция В Законодательном Собрании Красноярского края состоялась донорская акция, в которой приняли участие депутаты и сотрудники аппарата краевого парламент …

Глава Красноярского края прокомментировал нападения на школы Нападения на школы в Красноярском крае требуют системной реакции. Резонансные происшествия последний дней прокомментировал глава региона Михаил Котюк …

Подростка на ВАЗе задержали со стрельбой на юге Красноярского края В Каратузском районе Красноярского инспекторы ДПС применили табельное оружие для задержания 17-летнего водителя, пытавшегося скрыться от преследовани …

Пожар в котельной произошел на западе Красноярского края Утром 20 января в селе Белый Яр Ачинского округа Красноярского края произошел пожар в котельной. …

Минздрав Красноярского края сообщил о пострадавших детях в ДТП В результате ДТП с микроавтобусом и грузовиком в Красноярском крае пострадали семь человек, из них шесть несовершеннолетних. Об этом сообщили в пресс …

В еще одной деревне Красноярского края появился доступ к 4G МегаФон стал первым оператором связи, который установил базовую станцию в Ковригино Сухобузимского муниципального округа, обеспечив жителей доступом …

«Ростелеком» усилил безопасность на дорогах Красноярского края «Ростелеком» завершил проект по установке 80 стационарных постов фотовидеофиксации нарушений правил дорожного движения в Красноярском крае. …

«Крузер» автопьяницы из Красноярского края отправили в зону СВО Житель Красноярского края лишился «Крузера» за неоднократное вождение в пьяном виде. …

Таджикистанца осудили за смертельное ДТП на западе Красноярского края В Красноярском крае Ачинский городской суд признал гражданина Таджикистана виновным в нарушении правил дорожного движении, повлекшем по неосторожност …

НОВИКОМ разместил бюджетные средства Красноярского края НОВИКОМ (входит в холдинг «РТ-Финанс» — центр финансовых компетенций Госкорпорации Ростех) стал победителем первого конкурсного отбора на размещение …

Фальсификат нашли в колбасе производителя из Красноярского края В Красноярском крае аннулировали производственные сертификаты на 5,8 тонн колбасы. В них нашли признаки фальсификации. …

Обновлен дизайн социальной карты Красноярского края В рамках цифровизации Красноярского края стартовал выпуск социальных карт в современном оформлении. Теперь она стала красно-белой. …

Сборная Красноярского края готовится к Ярыгинскому турниру Сборная Красноярского края по вольной борьбе готовится к участию в международном турнире «Кубок Ивана Ярыгина». …

Четверо ветеранов СВО из Красноярского края стали управленцами В Красноярском крае четверо ветеранов СВО — участников региональной программы «Сибирский характер» — продолжат свою профессио …

Клещевыми инфекциями заболели уже 27 жителей Красноярского края С начала этого сезона в Красноярском крае зарегистрировано 8 заболевших клещевым вирусным энцефалитом, еще у 17 человек диагностирован боррелиоз и у …

Жителей Красноярского края приглашают на Всероссийский субботник Жителей Красноярска и края приглашают присоединиться к Всероссийской акции и привести в порядок дворы или общественные территории. …

Грузовой поезд зацепил КамАЗ на юге Красноярского края В Курагинском районе Красноярского края 62-летний водитель грузовика небезопасно остановился на ж/д переезде, из-за чего его зацепил поезд. …

Льготники Красноярского края получат 50% скидки на ж/д билеты С 1 мая 2025 года жители региона, относящиеся к определенным категориям льготников, получат возможность приобретать билеты на городские и пригородные …

МЧС Красноярского края подвело итоги новогодних праздников За 12-дневные новогодние выходные в Красноярском крае потушили 176 пожаров, в огне погибли 11 человек, травмы получили 8, спасены 17. …

Жителям Красноярского края рассказали об опасностях декабря Заместитель начальника ГУ МЧС Красноярского края Роман Ветчинников рассказал об основных рисках в декабре и о том, как безопасно пережить первый меся …

«Газпромнефть-СМ» расширяет поддержку промышленности Красноярского края Автор фото: Стоян Васев «Газпром нефть» и правительство Красноярского края договорились о расширении сотрудничества в сфере поставок моторных и индус …

Из минэкологии Красноярского края ушел замминистра по обращению с ТКО Распоряжением правительства Красноярского края от должности заместителя министра экологии региона — начальника отдела по обращению с отходами о …

Жители Красноярского края не смогут развестись 14 февраля Агентство ЗАГС Красноярского края учредило ежемесячные «дни без разводов». Первой датой стал День всех влюбленных. …

Учителям из Красноярского края присвоили почетные звания Более 60 учителей стали «Заслуженными работниками образования» и «Заслуженными педагогами» Красноярского края, а также получили федеральное звание «Н …

Жители Красноярского края за год пожаловались на коллекторов более 900 раз В 2024 году жители Красноярского края более 900 раз обратились в службу судебных приставов с жалобами на неправомерные действия кредиторов. …

В двух ДТП на трассах Красноярского края пострадали женщина и подросток 7 января в Красноярском крае в дорожных авариях с участием пяти автомобилей травмы получили два пассажира. …

У главного полицейского Красноярского края появился новый заместитель Начальник ГУ МВД по Красноярскому краю Александр Соловьёв представил личному составу региональной полиции своего нового заместителя — Алексея Ш …

Режим НМУ будут объявлять во всех городах Красноярского края С 1 марта в Красноярском крае все предприятия, имеющие источники выбросов, будут обязаны снижать нагрузку на атмосферный воздух в период неблагоприят …

Объем инвестиций в креативные индустрии Красноярского края вырос на 291% Системная государственная поддержка креативных индустрий позволит к 2030 году увеличить их долю в российской экономике до 6% …

Доверчивая пенсионерка из Красноярского края за день лишилась 6 млн рублей В Красноярском крае телефонные мошенники похитили у 68-летней жительницы Минусинска 6 млн рублей. …

Заказчикам Красноярского края рассказали об изменениях в сфере закупок 9 октября состоялся семинар для заказчиков Красноярского края, организованный ЭТП ГПБ (Электронная торговая площадка Газпромбанка). …

Клещи покусали еще более 1,5 тысяч жителей Красноярского края В Красноярском крае за прошедшую неделю к медикам с жалобами на присасывание клещей обратились 1 514 человек, из них детей — 391. …

КрасЖД отчиталась о выплатах в бюджеты Красноярского края и Хакасии В бюджет Красноярского края было направлено свыше 2,9 млрд рублей, в бюджет республики Хакасия — 511,7 млн. …

Ребенок выпал из окна дома на севере Красноярского края В Норильске Красноярского края мальчик возрастом 1 год 8 месяцев выпал из окна квартиры, расположенной на пятом этаже. …

В Заксобрании Красноярского края поздравили учителей с профессиональным праздником В Законодательном Собрании Красноярского края поздравили учителей с профессиональным праздником, который отмечается 5 октября. …

Мужчина погиб при пожаре в Бирилюсском районе Красноярского края Накануне поздно вечером в селе Новобирилюссы Красноярского края произошел пожар в жилом доме. …

На юге Красноярского края водитель выехал на встречку и погубил пассажирку В Красноярском крае 30 декабря произошло еще одно смертельное ДТП — на этот раз в Курагинском районе. …

Три пары из Красноярского края поженились на свадебном фестивале в Москве На Всероссийском свадебном фестивале «Россия. Соединяя сердца» заключили браки три пары из Красноярского края: Александр Трефилов и Викто …

Пожилая жительница Красноярского края заблудилась и 3 дня провела в лесу В Красноярском крае в районе села Отношка Казачинско-Пировского муниципального округа заблудилась женщина. …

МТС усилила сети на автодорогах и в малых городах Красноярского края МТС продолжает масштабную модернизацию сети мобильной связи в Красноярском крае. В результате проведенных работ... …

Школьников из Красноярского края приглашают на семинар по управлению дронами Специалисты Дивногорского техникума лесных технологий приглашают учащихся 9-х классов посетить практический семинар под названием «Дроны: автон …

Талантливые студенты Красноярского края получили именные стипендии В Красноярском крае председатель Законодательного Собрания Алексей Додатко и губернатор региона Михаил Котюков вручили свидетельства о присуждении кр …

Выбрана «краса» уголовно-исполнительной системы Красноярского края Оперуполномоченный оперативного отдела ИК-5 Елена Клоченко одержала победу в конкурсе «Краса УИС — 2024» в Красноярском крае. …

Инвестпроекты в АПК Красноярского края получили более 830 млн рублей господдержки Данное направление поддержки действует уже второй год. В прошлом году на эти цели было выделено 627 млн рублей. …

Двум районам Красноярского края назначили новых прокуроров В Красноярском крае прокурором Уярского района назначен советник юстиции Андрей Василенко, а прокурором Кежемского района — советник юстиции Ил …

МТС присоединила к своей сети еще 60 малых сел и деревень Красноярского края Больше всего малых деревень и сел было подключено в Ужурском, Манско-Уярском и Курагинском округах. …

«Дуэль» самцов маралов записала фотоловушка на юге Красноярского края Фотоловушка в Саяно-Шушенском заповеднике на юге Красноярского края сняла ночной поединок двух маралов. …

Клещи продолжают активно атаковать жителей Красноярского края В Красноярском крае за прошедшую неделю к медикам с жалобами на присасывание клещей обратились 126 жителей, что на 13 больше, чем за предыдущую. …

Жительница Красноярского края держала 4 детей в голоде и антисанитарии В городе Бородино Рыбинского района Красноярского края полицейские изъяли у матери 4 малолетних детей из-за угрозы их жизни и здоровью. …

Транспортная полиция Красноярского края поздравила детей с 1 июня В День защиты детей на объектах транспорта в Красноярском крае полицейские поздравляли ребят с началом лета и школьных каникул. …

Житель Красноярского края вымогал деньги у поклонников экс-жены В Красноярском крае 26-летнего жителя Канска будут судить за вымогательство денег у поклонников бывшей супруги. …

За неделю почти 11,5 тыс. жителей Красноярского края заболели ОРВИ В Красноярском крае за прошедшую неделю 11 446 жителей Красноярского края заболели ОРВИ. …

Жителя Красноярского края оштрафовали за запуск квадрокоптера над заповедником В Таймырском районе Красноярского края мужчину привлекли к административной ответственности за незаконное использование воздушного пространства над з …

Суд арестовал начальника отдела центра «Э» полиции Красноярского края Начальника отдела Центра противодействия экстремизму полиции Красноярского края подозревают в получении взятки в особо крупном размере. …

ГАИ на две недели взяла под особый контроль дороги Красноярского края В Красноярском крае из-за сильной аварийности на дорогах, в том числе со смертельным исходом, сотрудники Госавтоинспекции переведены на усиленный реж …

Депутаты Заксобрания Красноярского края согласовали рекомендации для правительства В Законодательном Собрании Красноярского края рассмотрели проект постановления о предложениях краевому правительству. …

Новые беспилотники закупили для защиты лесов Красноярского края Еще 5 беспилотников самолетного типа закупили для нужд лесной отрасли в Красноярском крае. …

В ЗАГСах Красноярского края будут поздравлять новоиспеченных родителей В отделах ЗАГС Красноярского края теперь будут проходить церемонии чествования родителей новорожденных детей. …

СК подтвердил, что семья из Красноярского края отравилась средством от насекомых Это приоритетная версия, которую сейчас рассматривает следствие. Следы инсектицида нашли в телах четверых детей, которые скончались от отравления. Сл …

На севере Красноярского края самолет выкатился за пределы полосы В аэропорту села Туруханск Красноярского края около 16:00 мск турбовинтовой самолет DHC-6 Twin Otter Series 400 авиакомпании «Арт Авиа» выкатился за …

На юге Красноярского края бобры устроили десятки новых «озер» В Курагинском округе Красноярского края бобры создали десятки новых «озер». О подготовке животных к зиме рассказали в Лесопожарном центре …

Поезд насмерть сбил мужчину на западе Красноярского края Грузовой поезд смертельно травмировал пешехода в районе станции Еловка на перегоне Снежница — Кача западного направления Красноярской железной …

Браконьер застрелил двух косуль на юго-востоке Красноярского края В Курагинском районе Красноярского края полицейские выявили факт незаконной охоты на сибирскую косулю. …

На севере Красноярского края белый медведь напал на людей В Таймырском-Долгано Ненецком районе местные жители оказали помощь семье, пострадавшей от нападения белого медведя. …

Спикер Заксобрания Красноярского края поздравил женщин с 8 Марта Председатель Законодательного Собрания Красноярского края Алексей Додатко поздравил женщин с Международным женским днем. …

Почти 80 % вывезенной из Красноярского края древесины уезжает в Китай За год в Китай из Красноярского края увезли больше 2,5 млн кубометров леса — это 78 % от всего объема экспорта. …

«Цифровая» карта Красноярского края приросла новой локацией с доступом к 4G Жители еще одной деревни в Красноярском крае получили доступ к современной сотовой связи. «МегаФон» стал первым... …

Судебные приставы Красноярского края выдворили больше 1200 мигрантов В 2024 году судебные приставы Красноярского края выдворили больше 1,2 тыс. мигрантов, нарушивших правила пребывания в РФ. …

Спикер Заксобрания Красноярского края поздравил с 8 Марта «серебряных» волонтёров Председатель Законодательного Собрания Красноярского края Алексей Додатко побывал в мастерской «Добро.Центр «Молоды душой» и поздра …

Врачи из Красноярского края удалили опухоль из груди 11-летней девочки Врачи из Красноярского края спасли 11-летнюю девочку, у которой обнаружили опухоль в груди. …

Задержан подозреваемый в смертельной аварии со школьным автобусом на юге Красноярского края Сотрудники минусинской полиции во взаимодействии с коллегами из Хакасии задержали 33-летнего жителя Абакана, подозреваемого в совершении ДТП со школь …

Жителей Красноярского края пригласили на соревнования сельских конников в Емельяново 6 сентября на ипподроме «Мустанг» в Емельяново пройдут юбилейные XXV краевые соревнования сельских конников. …

Бизнес-леди из Красноярского края отдала мошенникам более 21 млн рублей 58-летняя жительница Краснотуранского района Красноярского края стала жертвой мобильного мошенничества в особо крупном размере — аферисты созда …

Космонавт из Красноярского края Кирилл Песков показал Енисей и Ангару с МКС Космонавт Кирилл Песков показал Сибирь, в том числе Красноярский край, из иллюминатора МКС. …

2,4 миллиона трудоустроенных: результаты 34 лет работы службы занятости Красноярского края 11 июля служба занятости населения Красноярского края отмечает 34 года со дня основания. За это время при её поддержке нашли работу 2,4 миллиона чело …

МЧС предупредило жителей Красноярского края о грозах, граде и шквалистом ветре В воскресенье и понедельник в Туруханском районе, в центральных и южных районах Красноярского края и в Эвенкии местами ожидаются сильные и очень силь …

По делу о хищении 2 млрд руб. арестован глава госпредприятия Красноярского края ЦТЛ Суд заключил под стражу по 27 января 2026 года директора госпредприятия Красноярского края «Центр транспортной логистики» (ЦТЛ) Андрея Августиновича, …

Жители Красноярского края за год направили дорожникам свыше 2 тысяч обращений В 2025 году дорожники получили более 2 тыс. обращений от жителей Красноярского края через социальные сети и портал «Госуслуги». …

У жителя Красноярского края нашли незаконный арсенал оружия и боеприпасов В Шарыповском округе Красноярского края полицейские изъяли у жителя села Большое Озеро незаконно хранившиеся оружие и боеприпасы. …

Гендиректор зеленогорского ЭХЗ накануне 90-летия Красноярского края поздравил его жителей В Красноярском крае уже стартовали мероприятия, посвященные празднованию 90-летия со дня образования региона. …

Пьяная жительница Красноярского края избила дочь участника СВО из-за неприязни В Красноярском крае по иску прокуратуры суд взыскал с жительницы Ирбейско-Саянского округа компенсацию морального вреда в пользу дочери участника СВО …

Попавший в ДТП грузовик заблокировал участок трассы на западе Красноярского края В Ачинском районе Красноярского края временно ограничено движение транспорта на 674 км федеральной автодороги Р-255 «Сибирь». …

Экс-министр здравоохранения Красноярского края стала замглавы Минздрава Подмосковья Наталия Говорушкина, которая в течение почти 8 месяцев являлась министром здравоохранения Красноярского края, получила новую должность в минздраве Мо …

Жителям севера Красноярского края рекомендовали не выходить на подледную рыбалку На севере Красноярского края ожидаются неблагоприятные гидрологические явления, сообщили в пресс-службе регионального МЧС. …

В тайге Красноярского края искали мужчин, уехавших три дня назад за дровами В Красноярском крае специалисты Богучанского поисково-спасательного отряда обнаружили в лесу двух мужчин, которые 28 ноября уехали за дровами. …

Космонавт из Красноярского края Кирилл Песков готовится к возвращению на Землю Космонавт из Красноярского края Кирилл Песков готовится к возвращению на Землю вместе с другими членами экипажа миссии Crew-10. …

Экс-депутата из Красноярского края Романа Гольдмана объявили в международный розыск Экс-депутат Законодательного Собрания Красноярского края Роман Гольдман разыскивается по международным каналам по запросу России. …

Жительницу Красноярского края обвинили в тяжком преступлении 21-летней давности В Красноярском крае 56-летней жительницы Ачинска предъявлено обвинение в смертельном избиении сожителя скалкой, совершенном осенью 2024 года. …

На юге Красноярского края велосипедист насобирал конопли и сразу же попался полицейским В поселке Ильичево Шушенского района Красноярского края задержали велосипедиста с наркосодержащим растением. …

За 2026 год из аварийного жилья планируют переселить 1,8 тыс. жителей Красноярского края В Красноярском крае по программе переселения из аварийного жилья нацпроекта «Инфраструктура для жизни» планируется переселить не менее 1, …

На станции Кошурниково Красноярского края сошли с рельсов два вагона и локомотив Вечером 26 апреля, в 22:00 по местному времени (18:00 мск), на станции Кошурниково Красноярской железной дороги произошёл сход с рельсов двух хвостов …

17 школ из Красноярского края получат деньги на реализацию родительских инициатив Школы из Красноярского края получат премии на Всероссийском конкурсе инициатив родительских сообществ. …

МТС внедрила датчики контроля микроклимата на крупнейших месторождениях Красноярского края Цифровые технологии МТС обеспечат температурный контроль хранения продуктов питания для тысячи вахтовиков. …

Житель Красноярского края попытался поменять в ГАИ купленные в интернете права Житель Минусинского района Красноярского края обратился в Госавтоинспекцию, чтобы поменять фальшивые права на настоящие, сообщает пресс-служба МВД по …

В магазинах Красноярского края выявили опасный напиток «Алоэ Вера» В торговых точках четырех территорий Красноярского края специалисты Роспотребнадзора выявили партию опасного напитка «Алоэ Вера». …

Работникам из Красноярского края выплатили свыше 630 млн рублей долгов по зарплате В 2025 году прокуратура Красноярского края поставила на особый контроль проблему с невыплатой зарплат. …

На региональных трассах Красноярского края появятся первые беспроводные видеокамеры В этом году в Красноярском крае на региональных трассах установят первые 50 беспроводных камер видеофиксации, сообщили в КрУДор. …

Жители Красноярского края выиграли более 62 млн рублей в новогодней лотерее Совокупная сумма выигрышей жителей Красноярского края в новогоднем тираже «Русского лото» составила 62 348 108 рублей. …

Начинающие фермеры Красноярского края могут получит грант до 7 млн рублей Господдержка начинающему фермеру на молочное и мясное животноводство может составить до 7 млн рублей. …

«Ростелеком» приступил ко второму этапу цифровизации севера Красноярского края В июне 2025 г. «Ростелеком» начал второй этап строительства волоконно-оптической линии связи (ВОЛС) на севере Красноярского... …

Врачи из Красноярского края отчитались о работе в подшефном Свердловском округе Врачи из Красноярского края больше месяца оказывают помощь жителям Свердловского округа, а также военным, находящимся на лечении. …

В Богучанском районе Красноярского края подтопило автодорогу: движение закрыто В Богучанском районе Красноярского края река Каменка вышла из берегов и подтопила дорогу «Манзя — Каменка». …

Минобр рассказал о праздновании последних звонков в школах Красноярского края В Красноярском крае в этом году последние звонки в школах пройдут в единый день — 24 мая. …

Кибермошенники за неделю выманили у жителей Красноярского края более 48 млн рублей За прошедшую неделю интернет-преступники обманули 204 жителей Красноярского края и дистанционным способом похитили у них более 48 млн рублей. …

Министр строительства Красноярского края стал фигурантом уголовного дела Министр строительства и жилищно-коммунального хозяйства Михаил Заскалько стал фигурантом уголовного дела. …

Уголовное дело возбудили из-за холода в одной из больниц Красноярского края Уголовное дело по статье об оказании услуг, не отвечающих требованиям безопасности жизни и здоровья потребителей, возбуждено из-за низких температур …

Жители Красноярского края могут бесплатно проверить репродуктивное здоровье В Красноярском крае жители в возрасте от 18 до 49 лет могут пройти бесплатный скрининг состояния репродуктивного здоровья. …

На юге Красноярского края полицейский обстрелял колеса ВАЗа с водителем-бесправником В Шушенском муниципальном округе Красноярского края экипажу ДПС пришлось применить табельное оружие для остановки автомобилиста, не имеющего прав. …

Школьников из Красноярского края бесплатно научат работать с искусственным интеллектом Министерство цифрового развития, связи и массовых коммуникаций РФ приглашает школьников и студентов из Красноярского края к участию в программе «Код …

Депутаты Заксобрания Красноярского края обсудили предоставление соцуслуг в селах В Красноярском крае прошло совместное заседание комитета по охране здоровья и социальной политике Законодательного Собрания и секции Координационного …

Спикер Заксобрания поздравил жителей Красноярского края с Новым годом Спикер Законодательного Собрания Красноярского края Алексей Додатко поздравил жителей региона с наступающим Новым годом. …

Спасший товарища ветеран СВО из Красноярского края учится у главы приставов В Красноярске судебный пристав и ветеран спецоперации Алексей Блинов повышает квалификацию по кадровой программе «Сибирский характер». …

В кадровую программу Красноярского края для участников СВО подали заявки 399 человек На участие в кадровой программе Красноярского края «Сибирский характер» подали заявки 399 человек. …

Глава Красноярского края исполнил новогодние желания нескольких детей Все дети Красноярского края, чьи шарики снял с «Ёлки желаний» губернатор Михаил Котюков, получили подарки, о которых мечтали. …

Депутаты Заксобрания Красноярского края рассказали о своих семейных традициях Ко Дню семьи, любви и верности Законодательное Собрание Красноярского края запустило медиапроект «Семейный код». Он посвящен традициям, к …

Глава полиции Красноярского края подарил школьнику умную колонку Начальник ГУ МВД по Красноярскому краю Александр Соловьёв исполнил мечту юного красноярца в рамках Всероссийской акции «Ёлка желаний». …

«С господдержкой проще»: фермеры Красноярского края получили гранты «Агростартап» В Красноярском крае девять фермеров получили гранты «Агростартап» на создание и развитие своего дела. …

«Ростелеком» проложил «оптику» до старинной деревни на севере Красноярского края «Ростелеком» проложил волоконно-оптическую линию связи (ВОЛС) до деревни Колмогорово в Енисейском районе Красноярского края. …

Минсельхоз Красноярского края требует с консультационного центра для фермеров 31,2 млн рублей В Красноярском крае министерство сельского хозяйства через суд добивается возвращения незаконно выданных субсидий на сумму в 31,2 млн рублей. …

Спикер Заксобрания Красноярского края прокомментировал принятый накануне бюджет Спикер Законодательного Собрания Красноярского края Алексей Додатко прокомментировал принятый накануне в первом чтении бюджет региона на 2025 год. …

Музеи из Красноярского края получили гранты на развитие инклюзивной среды Фонд социальной помощи и поддержки «Свет» подвел итоги грантового конкурса для музеев «Без исключения—2024». …

Полпред президента вручил государственные награды жителям Красноярского края Полномочный представитель президента РФ в Сибирском федеральном округе Анатолий Серышев вручил госнаграды жителям Красноярского края. …

В Законодательном Собрании Красноярского края обсудили вопросы развития туризма В Законодательном Собрании Красноярского края обсудили вопросы развития туризма и детско-юношеского спорта в Шарыповском муниципальном округе. …

Жительницу Красноярского края осудили за обман касс самообслуживания в магазине В Красноярском крае привлекли к административной ответственности 31-летнюю жительницу Зеленогорска, которая использовала кассы самообслуживания в суп …

День траура объявлен в округе Красноярского края после ДТП с автобусом В Канском округе Красноярского края 6 февраля объявлено днем траура. Причина — гибель в ДТП пяти местных жителей.В день траура во всём округе будут п …

Жители Красноярского края массово устанавливают запрет на сделки с недвижимостью Управление Росреестра по Красноярскому краю зафиксировало значительный рост числа обращений собственников недвижимости, желающих защитить свое имущес …

СФУ внедряет отечественную платформу RITM³ для цифрового моделирования транспорта Красноярского края Simetra передала СФУ российскую платформу RITM³. Теперь специалисты университета будут использовать её, чтобы улучшать... …

Чиновник и риелтор задержаны за махинации с жильем для сирот на севере Красноярского края В Красноярском крае заместитель заведующего отделом управления образования администрации Таймырского Долгано-Ненецкого округа и 39-летний риелтор обв …

Ушел из жизни бывший депутат Заксобрания Красноярского края Юрий Страшников Ушел из жизни бывший депутат Заксобрания и замначальника УФСБ по Красноярскому краю Юрий Страшников. …

Мстительную жительницу Красноярского края осудили за сотню ложных доносов на полицию В Красноярском крае суд приговорил жительницу Уяра к штрафу за серию заведомо ложных обвинений полицейских в краже денег и документов. …

Билайн расширил покрытие 4G в более чем 30 малых населенных пунктах Красноярского края Уверенный сигнал 4G теперь доступен в Мотыгино, где находится единственный в России драмтеатр в поселке численностью менее 5 тысяч человек. …

Редкий краснокнижный гусь попал в объектив фотоловушки на севере Красноярского края В заповеднике на севере Красноярского края обнаружили краснокнижного сибирского таёжного гуменника. Птица попала в объектив фотоловушки. …

В 2026 году диспансеризацию могут пройти около 1,8 млн жителей Красноярского края Минздрав Красноярского края ожидает, что в 2026 году диспансеризацию пройдет около 1,8 млн жителей региона. …

Более 3,6 тысяч студентов-медиков вышли на практику в больницы Красноярского края Более 3,6 тыс. студентов Красноярского медицинского университета помогают врачам в 300 медорганизациях края и соседних регионов. …

«Ростелеком» запустил 11 базовых станций в малых населенных пунктах Красноярского края За первые шесть месяцев 2025 года «Ростелеком» построил и ввел в эксплуатацию 11 базовых станций в малых труднодоступных населенных пунктах Красноярс …

Производителя молока из Красноярского края просят наказать за использование сомнительного сырья Красноярский Россельхознадзор просит привлечь к ответственности местного производителя молока ООО «Млада» за нарушение технических реглам …

Житель Красноярского края признался в краже запасов домашнего вина у соседей На севере Красноярского края полицейские раскрыли кражу домашнего вина, сообщили в пресс-службе краевой полиции. …

Житель Красноярского края зарезал своего отца из-за подозрений в желании его убить В Ужурском районе Красноярского края суд арестовал 23-летнего местного жителя, подозреваемого в убийстве своего отца. …

Жительница Красноярского края отсудила более 100 тыс. рублей за навязанные услуги в автосалоне В Красноярском крае жительнице Иланского района выплатят более 100 тысяч рублей за навязанные услуги в автосалоне. …

Локомотив и вагоны с углем сошли с рельсов в Курагинском районе Красноярского края На Красноярской железной дороге при отправлении грузового поезда со станции Кошурниково произошел сход с пути двух вагонов, груженых углем, и маневро …

Предприниматели Красноярского края еще могут подать заявку на конкурс «Мой добрый бизнес» Конкурс был запущен для того, чтобы выявить и поддержать социальные предприятия, которые вносят значительный вклад в развитие общества. …

Жительница Красноярского края выплатила 1,5 млн рублей алиментов под угрозой уголовного дела Жительница Красноярского края, длительное время уклонявшаяся от выплат, полностью вернула долг в размере 1,55 млн рублей только после возбуждения уго …

Ветеранов СВО из Красноярского края будут учить министры соцполитики, медицины и образования В Красноярске стартовал социальный модуль образовательной программы для ветеранов спецоперации. …

В селе Красноярского края двое детей-пешеходов получили тяжкие травмы в ДТП В селе Богучаны Красноярского края 27-летний автомобилист сбил на «зебре» 11-летних мальчика и девочку. …

Парламент Красноярского края предложил упростить доступ аграриев к федеральным грантам Депутаты Законодательного Собрания Красноярского края предложили упростить доступ аграриев к федеральным грантам. …

Пожарные Красноярского края поздравили с Новым годом семью погибшего коллеги Сотрудники пожарной охраны Красноярского края навестили родителей своего коллеги, погибшего при исполнении служебного долга 30 лет назад. …

Нефтяники «РН-Ванкор» доставят на север Красноярского края миллион тонн грузов Главные логистические узлы для приема и разгрузки судов — три производственные базы на Таймыре, морские причалы в порту «Бухта Север&raqu …

«Ростелеком» обеспечил сотовой связью 58 отдаленных населенных пунктов Красноярского края В северных населенных пунктах, таких как Чиринда, Хантайское озеро, Суломай, Диксон, Вангаш, Полигус, Воронцово и Жданиха, базовые станции подключены …

Экс-чиновник из администрации губернатора Красноярского края попал в колонию за аферу с землей Суд отправил в колонию экс-замруководителя администрации губернатора и его сообщников за мошенничество с земельным участком. …

За выходные спасатели Красноярского края дважды снимали кольца с отекших пальцев В Красноярском крае за прошлые выходные спасателям пришлось снимать кольца с опухших пальцев сразу двум жительницам. …

Клещи продолжают нападать на жителей Красноярского края и заражать их опасными инфекциями В Красноярском крае за прошедшую неделю к медикам с жалобами на присасывание клещей обратились 106 человек. …

Жители Красноярского края за год собрали более 3 тыс. кубометров мусора с берегов водоемов В 2024 году жители Красноярского края очистили от мусора более 1,1 тыс. километров береговой линии водоемов. …

Младшеклассник попал в больницу после конфликта в одной из школ Красноярского края Сотрудники полиции выясняют обстоятельства получения телесных повреждений 7-летним учеником одной из школ поселка Курагино Красноярского края. …

Экс-начальник ГУ МВД Красноярского края Речицкий стал главным полицейским Ростовской области Бывший главный полицейский Красноярского края Александр Речицкий возглавил ГУ МВД по Ростовской области. …

Жительница Красноярского края отсудила у ателье двукратную стоимость утраченной шубы В Норильске Красноярского края владелица мехового ателье «Сияние Таймыра» вернула клиентке более 304 000 рублей за утраченную норковую шу …

Бюджет Красноярского края на 2026–2028 годы приняли в первом чтении В Законодательном Собрании Красноярского края в первом чтении приняли бюджет на 2026–2028 годы. …

В Минфине рассказали о параметрах бюджета Красноярского края на 2026-2028 годы В министерстве финансов Красноярского края рассказали о параметрах бюджета региона на 2026 год и плановый период 2026-2028 годов. …

Кошельки автомобилистов Красноярского края похудеют: транспортный налог готовится к взлёту С начала 2026 года в Красноярском крае планируется увеличение ставки транспортного налога. Величина повышения варьируется от 1,5 до 12 рублей за одну …

В Заксобрание внесли проект бюджета Красноярского края на 2026-2028 годы Правительство Красноярского края представило в Законодательное Собрание проект закона «О краевом бюджете на 2026 год и плановый период 2027-2028 годо …

Жители разных районов Красноярского края делятся снимками полярного сияния Необычное зрелище было доступно минувшим вечером и ночью жителям Красноярского края. Полярные сияния спровоцировала сильная магнитная буря уровня G4. …

В массовых новогодних гуляниях участвовало более 15 тысяч жителей Красноярского края В массовых гуляниях, посвященных празднованию Нового года, на елочных комплексах на территории Красноярского края приняли участие более 15 тысяч чело …

Четверо жителей Красноярского края попали в число освобожденных из украинского плена Депутат Госдумы от Красноярского края Юрий Швыткин рассказал в своем телеграм-канале об освобождении из украинского плена полутора сотен российских б …

В сентябре по измененному расписанию продолжат ходить 10 электричек на западе Красноярского края Две утренние электрички из Дивногорска, следующие до Минино и Зеледеево, весь сентябрь в эти дни недели будут ходить до ст. Красноярск. …
В сыре, котлетах и салате из Красноярского края специалисты нашли опасные бактерии Специалисты из Красноярского края нарушения в пяти пробах продуктов местных производителей. …

ЗАГС Красноярского края составил список красивых дат для свадьбы в 2025 году В агентстве ЗАГС Красноярского края поделились красивыми датами для свадьбы в следующем году. …

«Единая Россия» подготовила поправки ко второму чтению бюджета Красноярского края В основу поправки легли предложения депутатов, анализ обращений избирателей, приоритеты народной программы. …

Угольщики красноярского края завершили 2025 год историческим рекордом по объемам добычи Уверенно удерживает лидерские позиции Берёзовский разрез, отпраздновавший в 2025-году 50-летие, годовой производственный план горняки выполнили еще в …

Первый замглавы правительства РФ проверил работу крупных производств Красноярского края Первый заместитель председателя правительства Российской Федерации Денис Мантуров вместе с губернатором Михаилом Котюковым посетил крупные промышленн …

Второе за сутки ЧП в школах Красноярского края: трое доставлены в ожоговый центр По предварительным данным, поджог в школе могла устроить 14-летняя ученица. По сообщению РИА Новости, ее задержали. …

Поставщика продуктов питания для социальных учреждений Красноярского края признали недобросовестным Поставщик продуктов питания для социально значимых учреждений Красноярского края отказался исполнять контракты. …

Депутаты Заксобрания Красноярского края одобрили меры по поддержке многодетных семей В Красноярском крае депутаты Законодательного Собрания одобрили предложенные правительством меры по поддержке многодетных семей. …

Назван возможный виновник смертельной аварии со школьным автобусом на юге Красноярского края По предварительным данным правоохранителей, виновником ДТП с участием школьного автобуса и легковушки в Минусинском округе Красноярского края, являет …

На юге Красноярского края пенсионер потерялся в лесу и провел там почти двое суток В Минусинском районе Красноярского края полицейские нашли в лесу потерявшегося 67-летнего грибника из Хакасии. …

Жительницу Красноярского края осудили за дискредитацию российских военных на школьном собрании В Красноярском крае суд признал жительницу Нижнеингашского района виновной в публичных действиях, направленных на дискредитацию использования Вооруже …

Как «частные инвесторы» уничтожают жилищно-коммунальный комплекс северных посёлков Красноярского края В свирепые холода в предаварийном состоянии оказалась котельная одного из самых северных и удалённых от цивилизации посёлков России – Хатанги. Не спа …

Спикер Заксобрания Красноярского края поздравил жителей региона с Днем государственного флага Спикер Законодательного Собрания Красноярского края Алексей Додатко поздравил жителей региона с Днем государственного флага. …

«Конкурс 14 человек»: семь блогеров Красноярского края попали в программу «Министерство контента» Семь блогеров из Красноярского края вошли в федеральную команду «Министерства контента», сообщили в пресс-службе правительства региона. …

Реализуемый в промышленных городах Красноярского края проект «Профклассы.ФМ» признан на российском уровне Профклассы.ФМ с прошлого учебного года начали действовать в 25 российских школах, среди которых пять в Красноярском крае. …

Кооперативы Красноярского края получат почти 52 млн рублей на закупку молока и мяса у населения Основное условие — кооперативы должны сохранить объём закупки сельхозпродукции к уровню прошлого года. …

В российском консульстве в Таиланде назвали причину смерти врача-хирурга из Красноярского края Российский врач-хирург из Красноярского края погиб в результате падения с высоты в курортном таиландском городе Паттайя. …

Судебные приставы арестовали коллекцию оружия у жителя Красноярского края за долг в 15,8 млн рублей В Ачинском районе судебные приставы арестовали огнестрельное оружие у местного жителя, который задолжал более 15,8 млн рублей за незаконную охоту. …

Совет отцов Красноярского края поддержал идею запрета абортов без согласия мужа Представитель родительской общественности в Красноярском крае поддержал инициативу Патриарха Кирилла запретить аборты замужним женщинам без письменно …

В одном из городов Красноярского края у четверых водителей с психическими заболеваниями отобрали права По требованию прокуратуры Красноярского края суд лишил водительских прав четверых жителей Иланского с психическими заболеваниями. …

«Стабильный спрос на отечественную продукцию»: предприятия Красноярского края увеличили производство сыра По производству молока и молочной продуктивности коров край в числе лидеров в Сибирском федеральном округе. …

Золотодобытчики из Красноярского края стали героями нового документального фильма Валдиса Пельша За 114 дня съемочная группа побывала в четырех регионах России, преодолела суммарно более 50 000 километров — по воздуху, зимникам, карьерным д …

Сенатор Александр Усс оценил перспективы переработки бурого угля на территории Красноярского края В 2013 году угольщики начали производить из термококса брикетированное топливо для металлургии, а в 2017-м здесь запустили в производство бездымное т …

Предприниматели Красноярского края могут получить денежный бонус на продвижение своего бизнеса Цель программы — помочь предпринимателям начать продвижение своего бизнеса и повысить его узнаваемость. …

Жителя Красноярского края строго осудили за содействие незаконной вырубке леса на 22,5 млн рублей В Красноярском крае жителя Зеленогорска приговорили к длительному лишению свободы за то, что он способствовал незаконной вырубке леса в составе прест …

«Человек уникальной судьбы»: Михаил Бенюмов стал Почетным гражданином Красноярского края Художественный руководитель Красноярского камерного оркестра Михаил Бенюмов получил высшую краевую награду. …

Возбуждено уголовное дело после гибели пятого ребёнка в семье из Красноярского края Уголовное дело о причинении смерти по неосторожности было возбуждено после гибели трёхмесячного младенца в семье из села Красная Сопка Красноярского …

Врачи рассказали о выявленных болезнях у жителей Красноярского края при диспансеризации в 2024 году В 2024 году диспансеризацию прошли 1 миллион 135 тысяч взрослых жителей Красноярского края. …

Служба занятости населения Красноярского края обеспечивает кадрами предприятия приоритетных отраслей Для кадрового обеспечения за каждым работодателем закреплен персональный куратор, который ведет непрерывный подбор специалистов. …

Спикер Заксобрания Красноярского края принял участие в работе коллегии ФССП России В Красноярске состоялось пленарное заседание коллегии Федеральной службы судебных приставов (ФССП) России. В его работе принял участие спикер Законод …

Михаил Котюков рассказал зампреду правительства РФ о социально-экономическом развитии Красноярского края Губернатор Красноярского края по видеоконференц связи принял участие в совещании по вопросам развития Сибири, прошедшем накануне под руководством зам …

Друзья погибшего в Таиланде врача-хирурга из Красноярского края назвали дату прощания В Красноярске завтра, 26 января, пройдет церемония прощания с пластическим хирургом Тимофеем Борисовым, который погиб в первый день своего отпуска в …

Спикер Заксобрания Красноярского края выступил на заседании Президиума Совета законодателей России Спикер Законодательного Собрания Красноярского края Алексей Додатко выступил на заседании Президиума Совета законодателей при Федеральном Собрании Ро …

Спасатели Красноярского края вызволили водителя из снежной ловушки в канун Нового года В последние часы года в Шарыповском округе спасатели эвакуировали водителя, чей автомобиль застрял в снегу. А в первые часы 1 января другой отряд уже …

«Полный восторг!»: школьники из Красноярского края участвуют в образовательно-профориентационном интенсиве в Сочи Среди участников смены 20 ребят из городов ответственности СУЭК-Красноярск и СГК: Красноярска, Назарово, Шарыпово, Бородино и Минусинска. …

Житель Красноярского края купил в интернете сомнительные виниры и смог вернуть деньги Специалисты Красноярского Роспотребнадзора помогли жителю Норильска вернуть деньги за накладные виниры сомнительного качества, а также отсудить компе …

Глава пресс-службы полиции Красноярского края перевелся на работу в другой регион Владимир Юрченко уже покидал свой пост в ноябре 2021 года в связи с уходом на пенсию. На его должность тогда была назначена капитан внутренней службы …

«Облил бензином и поджег»: жителя Красноярского края осудили за жестокое убийство сожительницы Жителя Красноярского края осудили на 12 лет колонии за жестокое убийство сожительницы. …

В региональном конкурсе «Семья года — 2025» победили десять семей из Красноярского края В Красноярском крае рассказали об итогах регионального этапа Всероссийского конкурса «Семья года — 2025». …

Михаил Котюков вручил сотрудникам предприятий СУЭК награды к юбилею Красноярского края В преддверии 90-летнего юбилея Красноярского края губернатор Михаил Котюков вручил почётные знаки жителям региона, внесшим значительный вклад в его р …

«Поддержка атлетов и команд»: «Норникель» и Минспорта Красноярского края заключили соглашение о сотрудничестве Горно-металлургическая компания «Норникель» и министерство спорта Красноярского края заключили соглашение о сотрудничестве. …

Музыканты из Красноярского края смогут бесплатно поучиться у IOWA и пройти кастинг в «МТС Лейбл» На курсе «Первый трек» преподают популярные музыканты: группа IOWA и артисты «МТС Лейбла» — коллективы Jane Air и Settlers. …

Ежедневно на защиту лесов на юге Красноярского края будет выходить почти тысяча человек В Красноярском крае южные территории края готовятся к пожароопасному сезону. Почти тысяча человек будет ежедневно выходить на патрулирование территор …

63 года без больничных. Воспитательница из Красноярского края попала в Книгу рекордов России и уволилась Воспитатель детского сада "Колокольчик" в Нижнем Ингаше Красноярского края Нина Зюськевич попала в Книгу рекордов России. Она имеет самый длинный неп …

«Ростелеком» запустил 11 базовых станций для жителей малых населенных пунктов Красноярского края За первые шесть месяцев 2025 г. «Ростелеком» построил и ввел в эксплуатацию 11 базовых станций в малых труднодоступных... …

Жительница Красноярского края отсудила почти двойную стоимость непройденных онлайн-курсов В Красноярском крае компания вернет жительнице Лесосибирска более 245 тысяч рублей за непройденные онлайн-курсы по веб-дизайну. …

«Помогаем друг другу расти»: производственники со всего Красноярского края побывали на заводе «Про-Ток» С визитом на площадках красноярской компании «Про-Ток» побывали руководители 30 производственных предприятий Красноярского края. …

Житель Красноярского края получил условный срок за незаконную добычу краснокнижного осетра Дудинский районный суд Красноярского края вынес приговор местному жителю за незаконный оборот осетра. …

Жители северных территорий Красноярского края получат гранты от «Норникеля» на социальные проекты В Красноярском крае неравнодушные жители Норильска и Таймыра получат грантовую поддержку от «Норникеля» на реализацию общественно полезны …

На юге Красноярского края администрация района незаконно сдала в аренду земли природного заказника В Красноярском крае по искам прокуратуры государству возвращены участки в границах заказника «Кебежский». …

Предприниматели Красноярского края еще могут подать заявку для участия в международных и межрегиональных выставках В 2023 году данной мерой поддержки воспользовались 120 представителей бизнеса, а в 2024 году — уже 128 самозанятых и предпринимателей. …

В 2025 году центры амбулаторной онкопомощи посетили более 220 тыс. жителей Красноярского края Более 220 тыс. посещений центров амбулаторной онкологической помощи состоялось в 2025 году в Красноярском крае. …

«Больше 7 тонн молока в год с одной коровы»: животноводы Красноярского края обеспечили рост надоев Такого показателя аграриям удалось добиться за счет применения современных технологий, племенной работы по сохранению и улучшению пород. …

Экспортерам Красноярского края на бесплатных семинарах расскажут о правовых основах бизнеса, маркетинге и коммуникации Уже в эту пятницу, 18 октября, в Красноярске пройдет очный семинар «Правовые основы экспорта». …

«Это целая жизнь!»: работник с 38-летним стажем получил звание «Заслуженный энергетик Красноярского края» Ведущий инженер «Красноярскэнерго» Эдуард Павлов был удостоен почетного звания «Заслуженный энергетик Красноярского края». …

Путин наградил почетного гражданина Красноярского края Рината Галеева медалью «Герой Труда РФ» Президент Владимир Путин вручил высокую государственную награду «Герой Труда Российской Федерации» гендиректору красноярского научно-прои …

Энергетики задействовали воздушную технику для устранения последствий урагана в отдаленных районах Красноярского края В связи с отсутствием ледовой переправы, бригады совершали облеты линий электропередачи в районе поселков Кирчиж, Тунуй, Александровка, Муслинка. …

СК прокомментировал слухи о принадлежности к секте Сергея Усольцева, пропавшего с семьей в тайге Красноярского края Официальных сведений о том, что Сергей Усольцев, который считается без вести пропавшим с женой и дочерью во время туристического похода в горах Парти …

«Угроза обрушения и террористические риски»: опасный недострой выявили в селе на западе Красноярского края Прокуратура Красноярского края потребовала ограничить доступ к заброшенному зданию в селе Красный Завод Боготольского района. …

«Мастер-классы, квесты и проекты»: старшеклассники Красноярского края принимают участие в Профсмене.ФМ в Сочи Образовательный кэмп в Сочи продлится больше двух недель и на это время запланирована масштабная программа. …

Предпринимателей Красноярского края приглашают на бесплатную конференцию «Перезагрузка экспорта — 2024: Вектор на услуги» Участники смогут обсудить ключевые вопросы с представителями исполнительной власти региона, институтами поддержки предпринимательства и экспорта и эк …

На севере Красноярского края пьяная женщина уснула с сигаретой в руках и чуть не сгорела заживо В Эвенкийском районе нетрезвая 44-летняя женщина уснула с сигаретой в руках и устроила пожар в собственной квартире. …

Онлайн-мошенники украли у жителей Красноярского края в 2025 году более 2,6 млрд рублей В прокуратуре Красноярского края рассказали об итогах 2025 года в области расследования преступлений, связанных с мобильным мошенничеством. …

На жительницу Красноярского края завели уголовное дело после попытки продать редкую птицу В Красноярском крае в отношении 40-летней жительницы Канска возбудили уголовное дело по подозрению в незаконном содержании и продаже хищной птицы, за …

Экс-председатель правительства Красноярского края Юрий Лапшин не смог обжаловать приговор по делу о метро Красноярский краевой суд отклонил доводы жалоб экс-председателя регионального правительства Юрия Лапшина и бывшего руководителя «Краевого транс …

В феврале Поезд здоровья КрасЖД совершит рабочую поездку по станциям 5 округов Красноярского края Февральская поездка передвижного консультативно-диагностического центра «Доктор Войно-Ясенецкий (Святитель Лука)» пройдет по станциям 5 о …

С начала года предприниматели и самозанятые Красноярского края получили льготные микрозаймы на сумму более 700 млн рублей Поддержка действует в рамках нацпроекта «Малое и среднее предпринимательство». …

«Ущерб может составлять 20 млн»: у жителя Красноярского края изъяли запрещенную к добыче рыбу и чёрную икру В Красноярском крае сотрудники енисейской ГАИ задержали автомобиль Toyota Land Cruiser, в котором перевозилось 360 килограммов рыбы осетровых пород и …

Садовые общества Красноярского края могут получить грант на покупку противопожарного оборудования и ремонт инфраструктуры Размер господдержки составит до 200 тысяч рублей. Подать заявку необходимо до 28 мая 2025 года. …

СК не смог допросить экс-жену и сына Сергея Усольцева, пропавшего с новой семьей в тайге Красноярского края В Красноярском крае продолжается расследование загадочного дела исчезновения семьи Усольцевых, которые считаются без вести пропавшими во время турист …

Министр экологии Красноярского края проверил реализацию федерального проекта «Экономика замкнутого цикла» на КрАЗе Министр экологии Красноярского края Владимир Часовитин побывал на Красноярском алюминиевом заводе и познакомился с технологией утилизации отходов и и …

«МегаФон» обеспечил связью жителей деревень в двух районах Красноярского края и участок трассы «Сибирь» «МегаФон» установил базовые станции в селе Бобровка Большеулуйского района и деревне Завировка Рыбинского района. …

Прокурор назвал желаемое наказание для отца погибших от отравления детей в Красной Сопке Красноярского края В Назарове прокурор запросил 2 года условного лишения свободы отцу четверых погибших в результате отравления инсектицидами детей. …

За какие заслуги экс-глава Фонда капремонта Михаил Попелышев удостоился рекордной для Красноярского края взятки Экс-глава Фонда капремонта Красноярского края Михаил Попелышев ближайшие семь лет проведет в колонии строгого режима. Это на треть меньше, чем запраш …

Во всероссийском конкурсе лучших проектов создания комфортной городской среды участвуют три шахтерских города Красноярского края В Бородино продолжили облагораживать ул. Ленина, в Шарыпово — расширяют Динопарк, а в Назарово благоустраивают экопарк «Березовая Роща&ra …

В топ самых «дорогих» вакансий Красноярского края в апреле попали водитель пожарного автомобиля, юрист и врач-фтизиатр В колледж ищут заместителя директора по учебной работе на зарплату от 120 тыс. руб. …

Губернатор пришел на первый урок в новой школе красноярского микрорайона Метростроитель В Красноярске начала работу новая школа № 161 в микрорайоне Метростроитель — сегодня у ребят и педагогов первый учебный день. …

«Понятное управление и высокая скорость работы»: новые мусоровозы «РОСТтех» выйдут в рейс в двух районах Красноярского края Две машины уже готовы к работе, как рассказали в компании «РОСТтех», это позволит перераспределить нагрузку и качественно отгружать ТКО. …

Губернатор озвучил приоритеты развития АПК Ставропольского края Губернатор Ставропольского края на пресс-конференции в ТАСС озвучил приоритеты развития агропромышленного комплекса региона. Напомним, Владимир Влади …

Губернатор Ставрополья вручил награды лучшим следователям края Губернатор Ставрополья Владимир Владимиров в преддверии 15-летия со дня образования Следственного комитета России поздравил следователей края с их пр …

Губернатор Ставрополья поздравил жителей края с Новым годом Жителей Ставрополья с Новым годом поздравил губернатор Владимир Владимиров. «Дорогие земляки! Сердечно поздравляю вас с Новым годом! В эти дни мы оце …

Губернатор Алтайского края поздравил женщин с 8 Марта. Видео Губернатор Алтайского края Виктор Томенко поздравил жительниц региона с 8 Марта. Он опубликовал его на своей странице в соцсети "ВКонтакте". "Дорогие …

Губернатор Махонин рассказал Путину о развитии Пермского края Президент РФ Владимир Путин 10 марта провел в Кремле встречу с губернатором Пермского края Дмитрием Махониным. Губернатор доложил главе государства о …

Губернатор Приморского края и глава Владивостока проинспектировали стройки Губернатор Приморского края Олег Кожемяко и глава Владивостока Константин Шестаков проверили, как идёт строительство социально важных объектов в стол …

Губернатор призвал поддержать Ставрополь во всероссийском конкурсе Губернатор Владимир Владимиров призвал земляков поддержать Ставрополь во Всероссийском конкурсе "Культурная столица России". Ставрополь может стать к …

Губернатор Ярославской области призвал воздержаться от поездок по М-8 Губернатор Ярославской области Михаил Евраев призвал водителей отказаться от поездок по трассе М-8 Москва — Архангельск из-за парализованного движени …